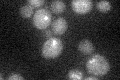
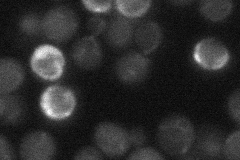
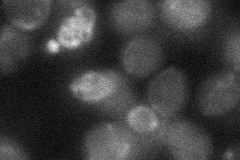

View description
Protein kinase that forms a complex with Mad1p and Bub3p that is crucial in the checkpoint mechanism required to prevent cell cycle progression into anaphase in the presence of spindle damage, associates with centromere DNA via Skp1p
Localization:
Intensity:
Fold change:
Significance:
-
C’ GFP library in SD
punctate17.1 -
N' NOP1pr-GFP in SD

punctate,nucleus27.2752 -
N' TEF2pr-mCherry in SD

punctate,nucleus9.05546 -
N' NATIVEpr-GFP in SD
below threshold18.9173 -
N' TEF2pr-VC and Cyto-VN in SD
below threshold25.2196 -
C’ GFP library in SD+DTT

technical problem0N/ANo -
C’ GFP library in SD+H2O2

punctate20.541.2No -
C’ GFP library in Starvation Media

punctate17.511.02No -
C’ GFP library on the background of Pup2-DaMP

punctate -
C’ GFP library on the background of CCT mutant

punctate18.88481.10391No
